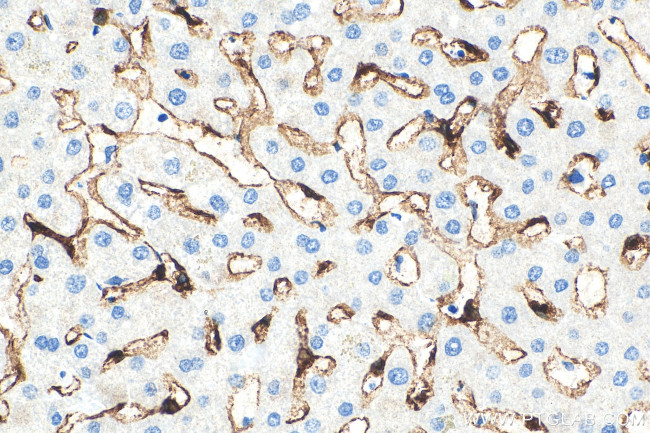
CLEC4G Antibody in Immunohistochemistry (Paraffin) (IHC (P))

Search
Proteintech
CLEC4G Polyclonal Antibody
{{$productOrderCtrl.translations['antibody.pdp.commerceCard.promotion.promotions']}}
{{$productOrderCtrl.translations['antibody.pdp.commerceCard.promotion.viewpromo']}}
{{$productOrderCtrl.translations['antibody.pdp.commerceCard.promotion.promocode']}}: {{promo.promoCode}} {{promo.promoTitle}} {{promo.promoDescription}}. {{$productOrderCtrl.translations['antibody.pdp.commerceCard.promotion.learnmore']}}
产品信息
18173-1-AP
种属反应
宿主/亚型
分类
类型
抗原
偶联物
形式
浓度
规格
纯化类型
保存液
内含物
保存条件
运输条件
产品详细信息
Immunogen sequence: GHDLLRTNA SKQTAALGAL KEEVGDCHSC CSGTQAQLQT TRAELGEAQA KLMEQESALR ELRERVTQGL AEAGRGREDV RTELFRALEA VRLQNNSCEP CPTSWLSFEG SCYFFSVPKT TWAAAQDHCA DASAHLVIVG GLDEQGFLTR NTRGRGYWLG LRAVRHLGKV QGYQWVDGVS LSFSHWNQGE PNDAWGRENC VMMLHTGLWN DAPCDSEKDG WICEKRHNC (66-293 aa encoded by BC093691)
靶标信息
This gene encodes a glycan-binding receptor and member of the C-type lectin family which plays a role in the T-cell immune response. Multiple transcript variants encoding different isoforms have been found for this gene.
仅用于科研。不用于诊断过程。未经明确授权不得转售。
篇参考文献 (0)
生物信息学
蛋白别名: C-type lectin domain family 4 member G; C-type lectin superfamily 4, member G; lectin; Liver and lymph node sinusoidal endothelial cell C-type lectin; LSECtin
基因别名: CLEC4G; DTTR431; LP2698; LSECtin; UNQ431; UNQ431/PRO792
UniProt ID: (Human) Q6UXB4
Entrez Gene ID: (Human) 339390